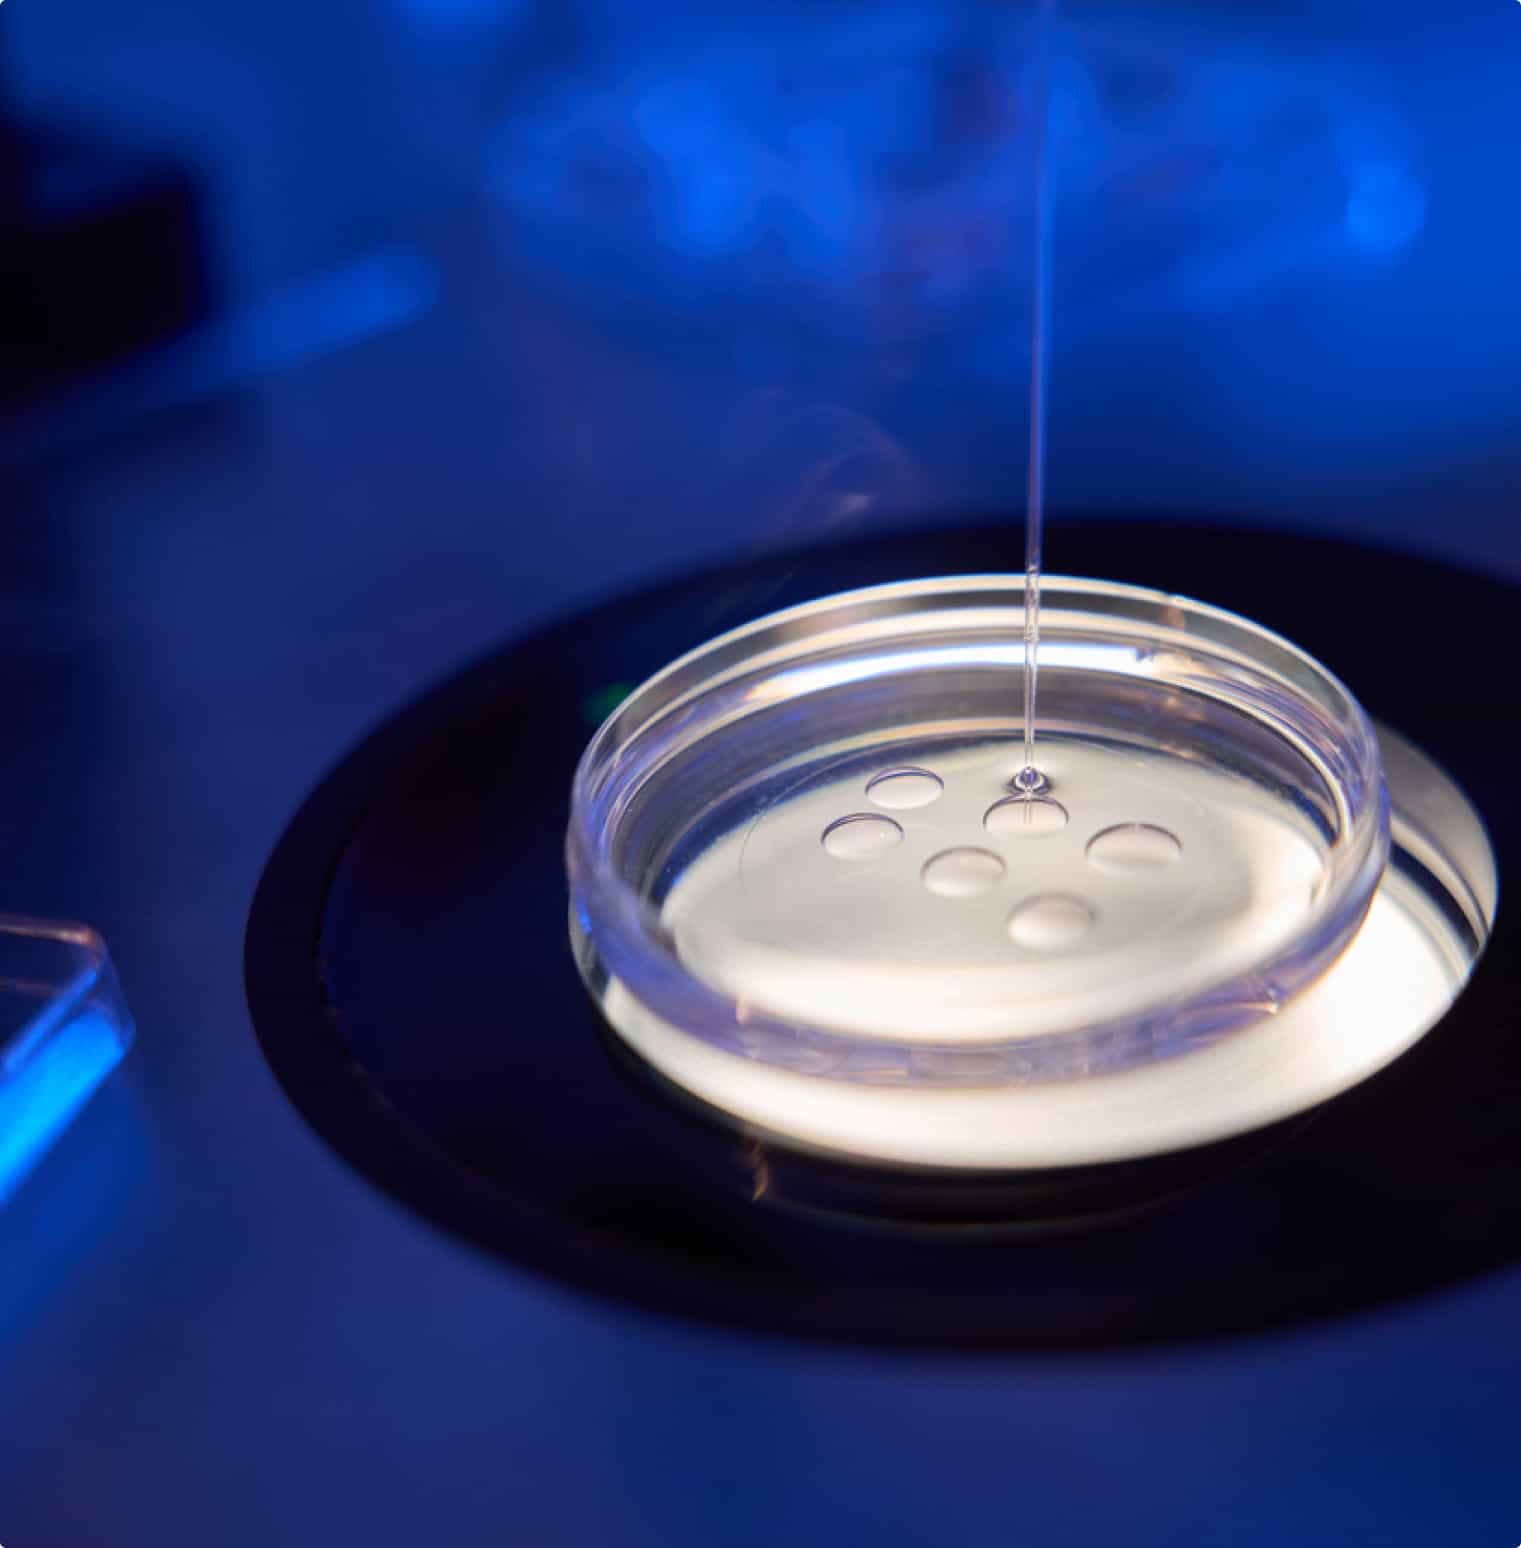
egg freezing

保存您的生育能力

冷冻卵子
取出卵子的方法与标准体外受精周期类似,唯一的不同是您的卵子会保持低温保存状态,直到需要受精为止,然后进行最终的胚胎移植。选择完成此操作可能有多种原因。
当今现代女性的生活方式选择
如今,越来越多的消息灵通的女性意识到自己与生俱来的需求(将来的某一天),同时希望在职业阶梯上向上攀升。冷冻卵子可以让你选择在停止生物钟的同时继续生活中的追求。如果你是一个尚未找到生活伴侣或打算使用伴侣的单身女性 当你准备好时,冷冻卵子可以让你在没有时间压力的情况下做出更广泛的选择。
卵子储备减少的早期发作
如果您面临自然或早期的卵巢储备减少,冷冻卵子是您在未来想要怀孕时的最佳选择。冷冻保存的卵子能够保持其质量,不受时间的影响。因此,早期了解我们的生育状况可以让我们在未来拥有更多的生育选择。建议20多岁的女性通过简单的方法来测量卵巢储备 。
健康状况问题或面临癌症挑战
现代医学已经能够提高对抗危及生命疾病甚至癌症患者的存活率。然而,一些治疗可能会影响或甚至使受影响患者的卵巢失去功能,从而危及她们未来的生育能力。卵子冷冻允许女性在克服严重健康问题后将卵子冷冻保存,以便在将来继续实现她们的生育目标。
冷冻精子
通常,在以下情况下,男性可能会选择冷冻精子:

在辅助受孕治疗期间缺席时
如果工作或旅行安排妨碍了您的IVF/IUI治疗,将精子冷冻以备后用可以提供便利。
面对医疗状况
在开始癌症治疗或不可避免的输精管切除手术之前,您可以保存精子样本,以便将来用于生育。
工作或生活方式的选择可能影响生育
如果你的工作有导致不育的风险或者如果你有接触/极限运动等爱好,那么保留精子作为未来的保险可能是个好主意。
卵巢组织冷冻
在保持生育能力方面的一项突破,如果你正在接受癌症或疾病的治疗,或者可能影响卵巢的身体创伤,你现在可以选择采集卵巢组织并保持低温保存状态。
Before treatment, the egg-producing tissue from your ovary is removed, frozen, and stored. After your medical treatment, the tissue can be re-implanted when you're ready to pursue your fertility goals.
Before treatment, the egg-producing tissue from your ovary is removed, frozen, and stored. After your medical treatment, the tissue can be re-implanted when you're ready to pursue your fertility goals.
